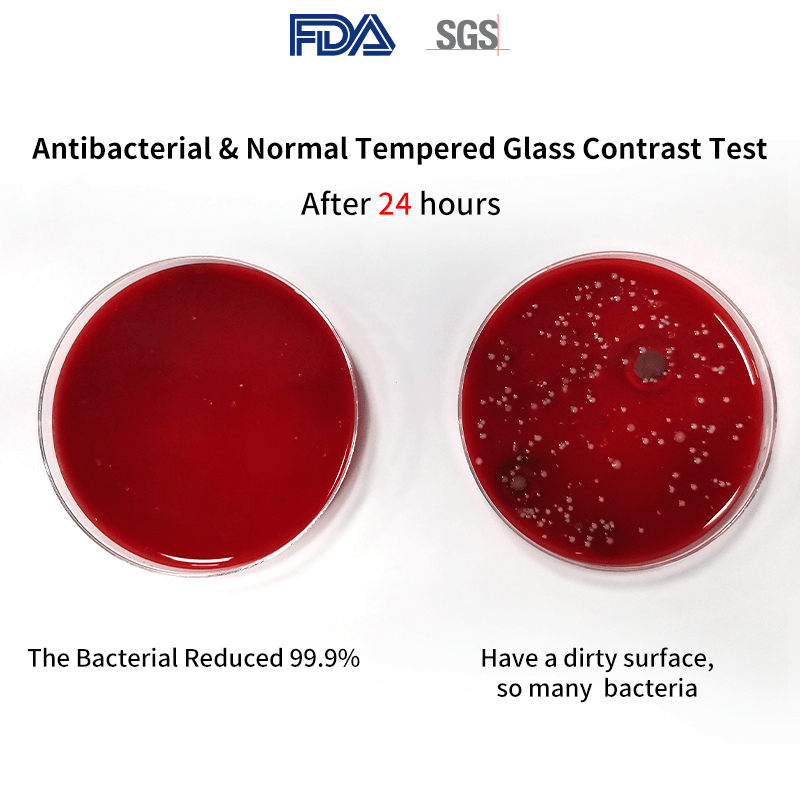
iPhone 12/ 12 Pro Anti Microbial 3D Screen Protector By T Max

Quick and easy online purchase for a fragrance I was struggling to find in store , thanks
Great glasses, as advertised
Great price
Fast efficient processing of my order

iPhone 12/ 12 Pro Anti Microbial 3D Screen Protector By T Max
iPhone 12 / 12 Pro
Gadgets Online Retail Store in Mount Eden
591 Dominion Road
Mount Eden
AUK
Auckland 1041
New Zealand
Choose options
Product Descriptions –
Function: Anti-scratch, Anti-Fingerprint, Anti-explosion, High Transparent, HD CLEAR, Antibacterial Screen Protector for Health
Compatible Model : For iPhone 12 / iPhone 12 Pro
Material: Tempered Glass, Antibacterial Glass
Radian: 2.5d
Quality: Grade AAA
Product name: Antibacterial Screen Protector
Thickness: 0.33mm
Transparency: 99% Highly Clear
Hardness: 9H
Product Features -
Anti-Microbial – Effectively inhibit common bacteria and prevent bacterial infestation
Anti-Fingerprint – Strong anti-fingerprint oil coating on the glass surface
Broken-Resistant – the Glass is strong treated and the edges are not brittle
9H Hardness – Effectively resist sharp objects and protect the phone screen
Included –
Anti-Bacterial Glass x 1, Dust Remover Sticker x 1, Cleaning Cloth x 1, Alcohol Cleaner x 1